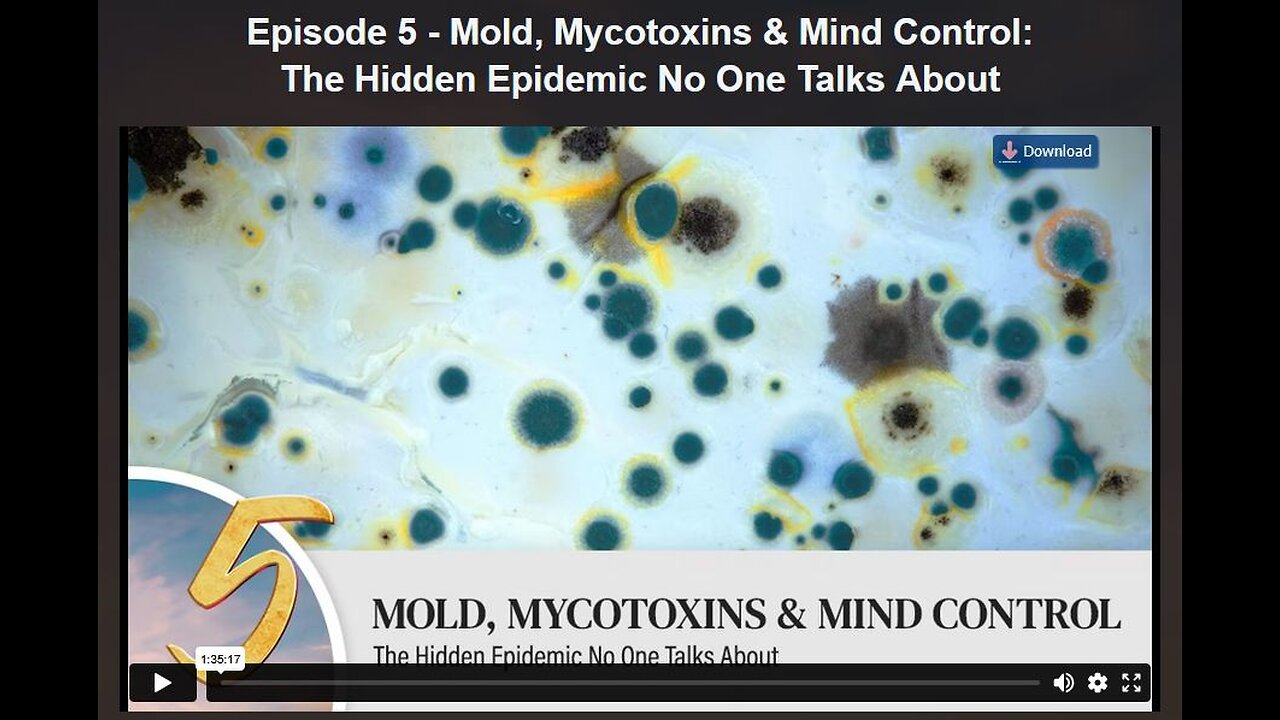
HEALING REVOLUTION SERIES: EPISODE 5- Mold, Mycotoxins & Mind Control: The Hidden Epidemic No One Talks About

Premium Only Content
This video is only available to Rumble Premium subscribers. Subscribe to
enjoy exclusive content and ad-free viewing.
HEALING REVOLUTION SERIES: EPISODE 5- Mold, Mycotoxins & Mind Control: The Hidden Epidemic No One Talks About
6 months ago
65
HEALING REVOLUTION SERIES: EPISODE 5- Mold, Mycotoxins & Mind Control: The Hidden Epidemic No One Talks About
Loading comments...
-
 14:05
14:05
Sideserf Cake Studio
22 hours ago $16.69 earnedHYPERREALISTIC HAND CAKE GLOW-UP (Old vs. New) 💅
59.7K11 -
 28:37
28:37
marcushouse
1 day ago $9.65 earnedSpaceX Just Dropped the Biggest Starship Lander Update in Years! 🤯
29.5K12 -
 14:54
14:54
The Kevin Trudeau Show Limitless
3 days agoThe Hidden Force Running Your Life
113K26 -
 2:16:35
2:16:35
DLDAfterDark
11 hours ago $10.00 earnedIs The "SnapPocalypse" A Real Concern? Are You Prepared For SHTF? What Are Some Considerations?
30.9K12 -
 19:58
19:58
TampaAerialMedia
22 hours ago $10.16 earnedKEY LARGO - Florida Keys Part 1 - Snorkeling, Restaurants,
46.1K21 -
 1:23
1:23
Memology 101
2 days ago $9.55 earnedFar-left ghoul wants conservatives DEAD, warns Dems to get on board or THEY ARE NEXT
36.4K73 -
 3:27:27
3:27:27
SavageJayGatsby
12 hours ago🔥🌶️ Spicy Saturday – BITE Edition! 🌶️🔥
61.2K7 -
 26:09
26:09
Exploring With Nug
22 hours ago $12.64 earned13 Cold Cases in New Orleans What We Discovered Beneath the Surface!
55.9K28 -
 27:39
27:39
MYLUNCHBREAK CHANNEL PAGE
17 hours agoDestroying Time.
138K43 -
 3:27:19
3:27:19
Mally_Mouse
12 hours ago🌶️ 🥵Spicy BITE Saturday!! 🥵🌶️- Let's Play: Minecraft Christmas Adventure!!
135K13